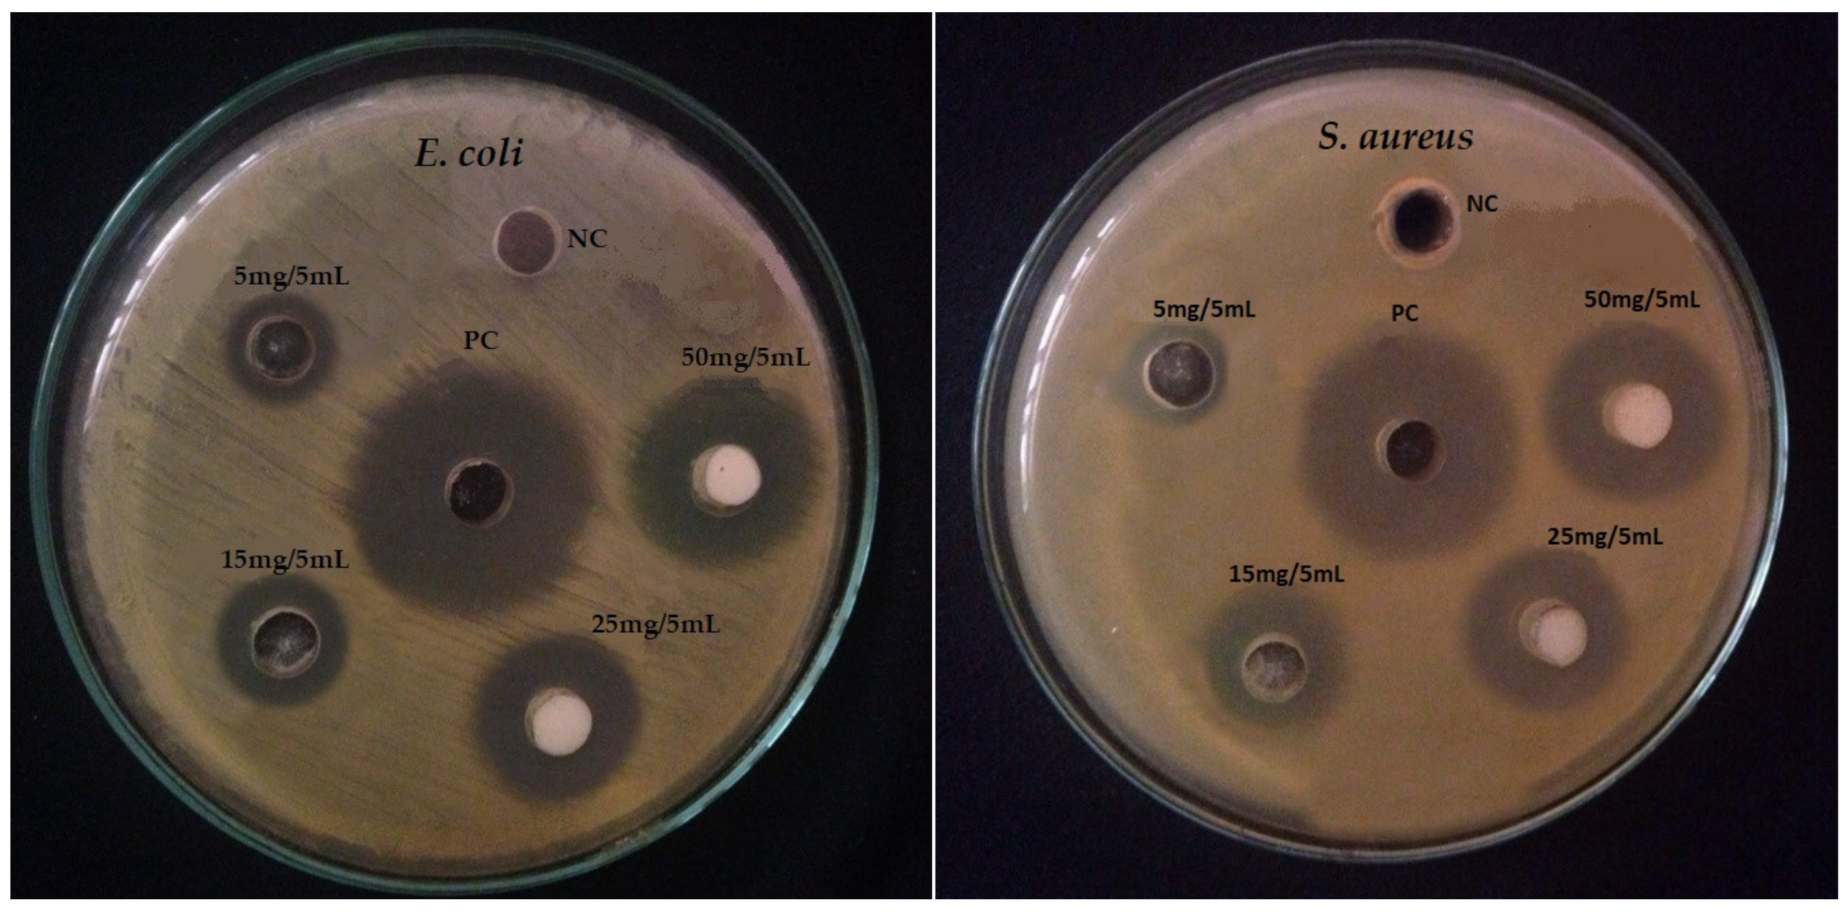
Materials 14 06085 g008

Bergenia ciliate–Mediated Mixed-Phase Synthesis and Characterization of Silver-Copper Oxide Nanocomposite for Environmental and Biological Applications
Abstract
:1. Introduction
2. Materials and Methods
2.1. Chemicals Used
2.2. Preparation of B. ciliata Leaf Extract
2.3. Synthesis of Ag-CuO NC
2.4. Instrumentation
2.5. Photocatalytic Assay
2.6. Antibacterial Assay
2.7. Antioxidant Assay
2.8. Statistical Measurements
3. Results and Discussion
3.1. Physicochemical Study
3.1.1. SEM Analysis
3.1.2. TEM Analysis
3.1.3. EDX Analysis
3.1.4. XRD Analysis
3.1.5. UV-Visible Analysis
3.1.6. FTIR Analysis
3.2. Photocatalytic Study
3.3. Antibacterial Activity
3.4. Antioxidant Activity
4. Conclusions
Author Contributions
Funding
Institutional Review Board Statement
Informed Consent Statement
Data Availability Statement
Acknowledgments
Conflicts of Interest
References
- Reza, K.M.; Kurny, A.; Gulshan, F. Parameters affecting the photocatalytic degradation of dyes using TiO2: A review. Appl. Water Sci. 2017, 7, 1569–1578. [Google Scholar] [CrossRef] [Green Version]
- Alavi, M.; Karimi, N. Antiplanktonic, antibiofilm, antiswarming motility and antiquorum sensing activities of green synthesized Ag–TiO2, TiO2–Ag, Ag–Cu and Cu–Ag nanocomposites against multi-drug-resistant bacteria. Artif. Cells Nanomed. Biotechnol. 2018, 46, S399–S413. [Google Scholar] [CrossRef] [Green Version]
- Catauro, M.; Barrino, F.; Blanco, I.; Piccolella, S.; Pacifico, S. Use of the Sol-Gel Method for the Preparation of Coatings of Titanium Substrates with Hydroxyapatite for Biomedical Application. Coat. Artic. 2020, 10, 203. [Google Scholar] [CrossRef] [Green Version]
- Yuan, X.; Floresyona, D.; Aubert, P.H.; Bui, T.T.; Remita, S.; Ghosh, S.; Brisset, F.; Goubard, F.; Remita, H. Photocatalytic degradation of organic pollutant with polypyrrole nanostructures under UV and visible light. Appl. Catal. B Environ. 2019, 242, 284–292. [Google Scholar] [CrossRef]
- Bharathi, E.; Sivakumari, G.; Kamalakkannan, J.; Karthikeyan, B.; Senthilvelan, S. Synergetic execute pressure, temperature on mixed Ac/Ag@CuO and its multi properties of solar light elucidation and antibacterial activity by hydrothermal technique. Mater. Sci. Energy Technol. 2020, 3, 407–419. [Google Scholar] [CrossRef]
- Khan, A.U.; Khan, A.U.; Li, B.; Mahnashi, M.H.; Alyami, B.A.; Alqahtani, Y.S.; Tahir, K.; Khan, S.; Nazir, S. A facile fabrication of silver/copper oxide nanocomposite: An innovative entry in photocatalytic and biomedical materials. Photodiagnosis Photodyn. Ther. 2020, 31. [Google Scholar] [CrossRef] [PubMed]
- Asamoah, R.B.; Annan, E.; Mensah, B.; Nbelayim, P.; Apalangya, V.; Onwona-Agyeman, B.; Yaya, A. A Comparative Study of Antibacterial Activity of CuO/Ag and ZnO/Ag Nanocomposites. Adv. Mater. Sci. Eng. 2020, 2020. [Google Scholar] [CrossRef]
- Ashrafi, M.; Bayat, M.; Mortazavi, P.; Hashemi, S.J.; Meimandipour, A. Antimicrobial effect of chitosan–silver–copper nanocomposite on Candida albicans. J. Nanostruct. Chem. 2020, 10, 87–95. [Google Scholar] [CrossRef] [Green Version]
- Roy, A.; Bulut, O.; Some, S.; Mandal, A.K.; Yilmaz, M.D. Green synthesis of silver nanoparticles: Biomolecule-nanoparticle organizations targeting antimicrobial activity. RSC Adv. 2019, 9, 2673–2702. [Google Scholar] [CrossRef] [Green Version]
- Salari, H.; Sadeghinia, M. MOF-templated synthesis of nano Ag2O/ZnO/CuO heterostructure for photocatalysis. J. Photochem. Photobiol. A Chem. 2019, 376, 279–287. [Google Scholar] [CrossRef]
- Rehana, D.; Mahendiran, D.; Kumar, R.S.; Rahiman, A.K. Evaluation of antioxidant and anticancer activity of copper oxide nanoparticles synthesized using medicinally important plant extracts. Biomed. Pharmacother. 2017, 89, 1067–1077. [Google Scholar] [CrossRef] [PubMed]
- Soltani, M.; Jamali-sheini, F.; Yousefi, R. Effect of growth condition on structure and optical properties of hybrid Ag-CuO nanomaterials. Adv. Powder Technol. 2016. [Google Scholar] [CrossRef]
- Wang, Z.; Lu, Q.; Wang, P.; Li, J. Structure and optical properties of ordered mesoporous copper oxide-silica composite films. J. Exp. Nanosci. 2011, 6, 528–538. [Google Scholar] [CrossRef]
- Anandalakshmi, K.; Venugobal, J.; Ramasamy, V. Characterization of silver nanoparticles by green synthesis method using Pedalium murex leaf extract and their antibacterial activity. Appl. Nanosci. 2016, 6, 399–408. [Google Scholar] [CrossRef] [Green Version]
- Shah, A.; Haq, S.; Rehman, W.; Muhammad, W.; Shoukat, S.; Rehman, M. Photocatalytic and antibacterial activities of Paeonia emodi mediated silver oxide nanoparticles. Mater. Res. Express 2019, 6, 045045. [Google Scholar] [CrossRef]
- Zarei, Z.; Razmjoue, D.; Karimi, J. Green Synthesis of Silver Nanoparticles from Caralluma tuberculata Extract and its Antibacterial Activity. J. Inorg. Organomet. Polym. Mater. 2020, 30, 4606–4614. [Google Scholar] [CrossRef]
- Hamid, A.; Haq, S.; Ur Rehman, S.; Akhter, K.; Rehman, W.; Waseem, M.; Ud Din, S.; Ul Abdin, Z.; Hafeez, M.; Khan, A.; et al. Calcination temperature-driven antibacterial and antioxidant activities of fumaria indica mediated copper oxide nanoparticles: Characterization. Chem. Pap. 2021, 75, 4189–4198. [Google Scholar] [CrossRef]
- Azam, A.; Oves, M. Size-dependent antimicrobial properties of CuO nanoparticles against Gram-positive and -negative bacterial strains. Int. J. Nanomed. 2012, 7, 3527–3535. [Google Scholar] [CrossRef] [Green Version]
- Aisida, S.O.; Ugwoke, E.; Uwais, A.; Iroegbu, C.; Botha, S.; Ahmad, I.; Maaza, M.; Ezema, F.I. Incubation period induced biogenic synthesis of PEG enhanced Moringa oleifera silver nanocapsules and its antibacterial activity. J. Polym. Res. 2019, 26, 225. [Google Scholar] [CrossRef]
- Modwi, A.; Taha, K.K.; Khezami, L.; Bououdina, M.; Houas, A. Silver decorated Cu/ZnO photocomposite: Efficient green degradation of malachite. J. Mater. Sci. Mater. Electron. 2019, 30, 3629–3638. [Google Scholar] [CrossRef]
- Haq, S.; Yasin, K.A.; Rehman, W.; Waseem, M.; Ahmed, M.N.; Shahzad, M.I.; Shahzad, N.; Shah, A.; Rehman, M.U.; Khan, B. Green Synthesis of Silver Oxide Nanostructures and Investigation of Their Synergistic Effect with Moxifloxacin Against Selected Microorganisms. J. Inorg. Organomet. Polym. Mater. 2020, 31, 1134–1142. [Google Scholar] [CrossRef]
- Shah, A.; Tauseef, I.; Ali, M.B.; Yameen, M.A.; Mezni, A.; Hedfi, A.; Haleem, S.K.; Haq, S. In-Vitro and In-Vivo Tolerance and Therapeutic Investigations of Phyto-Fabricated Iron Oxide Nanoparticles against Selected Pathogens. Toxics 2021, 9, 105. [Google Scholar] [CrossRef]
- Haq, S.; Rehman, W.; Waseem, M.; Meynen, V.; Awan, S.U.; Saeed, S.; Iqbal, N. Fabrication of pure and moxifloxacin functionalized silver oxide nanoparticles for photocatalytic and antimicrobial activity. J. Photochem. Photobiol. B Biol. 2018, 186, 116–124. [Google Scholar] [CrossRef] [PubMed]
- Haq, S.; Rehman, W.; Waseem, M.; Shah, A.; Khan, A.R. Green synthesis and characterization of tin dioxide nanoparticles for photocatalytic and antimicrobial studies. Mater. Res. Express 2020, 7, 025012. [Google Scholar] [CrossRef]
- Haq, S.; Dildar, S.; Ali, M.B.; Mezni, A.; Hedfi, A.; Shahzad, M.I.; Shahzad, N.; Shah, A. Antimicrobial and antioxidant properties of biosynthesized of NiO nanoparticles using Raphanus sativus (R. sativus) extract. Mater. Res. Express 2021, 8, 055006. [Google Scholar] [CrossRef]
- Haq, S.; Abbasi, F.; Ali, M.B.; Hedfi, A.; Mezni, A.; Rehman, W.; Waseem, M.; Khan, A.R.; Shaheen, H. Green synthesis of cobalt oxide nanoparticles and the effect of annealing temperature on their physiochemical and biological properties. Mater. Res. Express 2021, 8, 075009. [Google Scholar] [CrossRef]
- Haq, S.; Ahmad, P.; Khandaker, M.U.; Faruque, M.R.I.; Rehman, W.; Waseem, M.; Din, S.U. Antibacterial, antioxidant and physicochemical investigations of tin dioxide nanoparticles synthesized via microemulsion method. Mater. Res. Express 2021, 8, 035013. [Google Scholar] [CrossRef]
- Rehman, F.U.; Mahmood, R.; Ali, M.B.; Hedfi, A.; Mezni, A.; Haq, S.; Din, S.U.; Ehsan, R. Physicochemical, Photocatalytic, Antibacterial, and Antioxidant Screening of Bergenia Ciliata Mediated Nickel Oxide Nanoparticles. Crystal 2021, 11, 1137. [Google Scholar] [CrossRef]
- Ghorai, T.K.; Biswas, N. Photodegradation of rhodamine 6G in aqueous solution via SrCrO4 and TiO2 nano-sphere mixed oxides. J. Mater. Res. Technol. 2013, 2, 10–17. [Google Scholar] [CrossRef] [Green Version]
- Asiri, A.M.; Al-amoudi, M.S.; Al-talhi, A.D. Photodegradation of Rhodamine 6G and phenol red by nanosized TiO2 under solar irradiation. J. Saudi Chem. Soc. 2011, 15, 121–128. [Google Scholar] [CrossRef] [Green Version]
- Reddy, K.H.; Martha, S.; Parida, K.M. Fabrication of novel p-BiOI/n-ZnTiO3 heterojunction for degradation of rhodamine 6G under visible light irradiation. Inorg. Chem. 2013, 52, 6390–6401. [Google Scholar] [CrossRef] [PubMed]
- Lutic, D.; Coromelci-Pastravanu, C.; Cretescu, I.; Poulios, I.; Stan, C.D. Photocatalytic treatment of rhodamine 6G in wastewater using photoactive ZnO. Int. J. Photoenergy 2012, 2012, 475131. [Google Scholar] [CrossRef] [Green Version]
- Seery, M.K.; George, R.; Floris, P.; Pillai, S.C. Silver doped titanium dioxide nanomaterials for enhanced visible light photocatalysis. J. Photochem. Photobiol. A Chem. 2007, 189, 258–263. [Google Scholar] [CrossRef] [Green Version]
- Ali, M.B.; Barka-Bouaifel, F.; Elhouichet, H.; Sieber, B.; Added, A.; Boussekey, L.; Ferid, M.; Boukherroub, R. Hydrothermal synthesis, phase structure, optical and photocatalytic properties of Zn2SnO4 nanoparticles. J. Colloid Interface Sci. 2015, 457, 360–369. [Google Scholar] [CrossRef]

| S.No. | Nanocatalysts | Time (min) | Percentage Degradation | References |
|---|---|---|---|---|
| 1 | SrCrO4/TiO2 oxides | 360 | 95 | [20] |
| 2 | n-TiO2 | 180 | 11 | [21] |
| 3 | ZnTiO3 | 180 | 82 | [22] |
| 4 | ZnO and TiO2 | 90 | 71.41; 86.02 | [23] |
| 5 | Ag–TiO2 | 60 | 96.57 | [24] |
| 6 | Zn2SnO4 | 90 | 91 | [25] |
| 7 | Ag-CuO | 80 | 99.42 | Present work |
| Samples | Concentrations (μg·mL−1) | %RSA | IC50 Value (μg·mL−1) | Variance (S2) | Standard Deviation (S) | Correlation b/w the Obtained Data (p = 0.05) |
|---|---|---|---|---|---|---|
| Ag-CuO NC | 5 | 41.08 | 126.60 | 1.29 | 1.13 | 0.010632 |
| 25 | 49.38 | |||||
| 50 | 61.57 | |||||
| 75 | 76.63 | |||||
| 100 | 85.03 | |||||
| 200 | 96.88 | |||||
| Ascorbic Acid | 5 | 39.1 | 131.21 | 1.31 | 1.14 | |
| 25 | 49.05 | |||||
| 50 | 59.13 | |||||
| 75 | 71.49 | |||||
| 100 | 81.74 | |||||
| 200 | 94.62 |
Publisher’s Note: MDPI stays neutral with regard to jurisdictional claims in published maps and institutional affiliations. |
© 2021 by the authors. Licensee MDPI, Basel, Switzerland. This article is an open access article distributed under the terms and conditions of the Creative Commons Attribution (CC BY) license (https://creativecommons.org/licenses/by/4.0/).
Share and Cite
Rehman, F.U.; Mahmood, R.; Ali, M.B.; Hedfi, A.; Almalki, M.; Mezni, A.; Rehman, W.; Haq, S.; Afsar, H. Bergenia ciliate–Mediated Mixed-Phase Synthesis and Characterization of Silver-Copper Oxide Nanocomposite for Environmental and Biological Applications. Materials 2021, 14, 6085. https://doi.org/10.3390/ma14206085
Rehman FU, Mahmood R, Ali MB, Hedfi A, Almalki M, Mezni A, Rehman W, Haq S, Afsar H. Bergenia ciliate–Mediated Mixed-Phase Synthesis and Characterization of Silver-Copper Oxide Nanocomposite for Environmental and Biological Applications. Materials. 2021; 14(20):6085. https://doi.org/10.3390/ma14206085
Chicago/Turabian StyleRehman, Fazal Ur, Rashid Mahmood, Manel Ben Ali, Amor Hedfi, Mohammed Almalki, Amine Mezni, Wajid Rehman, Sirajul Haq, and Humma Afsar. 2021. "Bergenia ciliate–Mediated Mixed-Phase Synthesis and Characterization of Silver-Copper Oxide Nanocomposite for Environmental and Biological Applications" Materials 14, no. 20: 6085. https://doi.org/10.3390/ma14206085
APA StyleRehman, F. U., Mahmood, R., Ali, M. B., Hedfi, A., Almalki, M., Mezni, A., Rehman, W., Haq, S., & Afsar, H. (2021). Bergenia ciliate–Mediated Mixed-Phase Synthesis and Characterization of Silver-Copper Oxide Nanocomposite for Environmental and Biological Applications. Materials, 14(20), 6085. https://doi.org/10.3390/ma14206085







